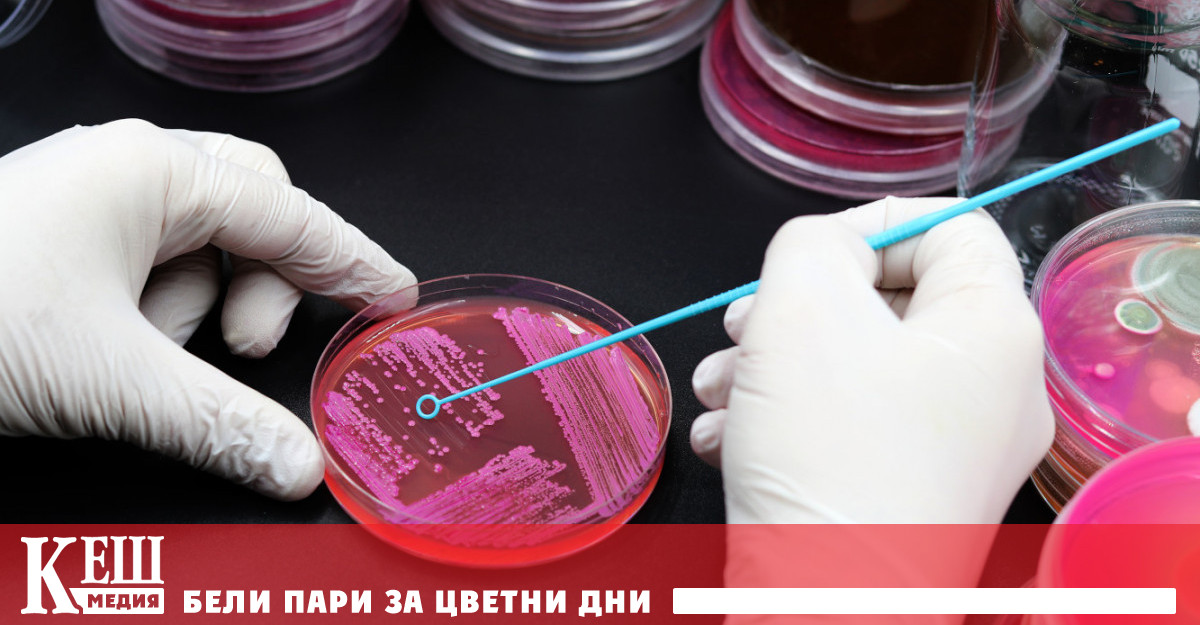
Освен това новият вид антибиотично съединение което е дело на

... които ще ни помогнат в борбата срещу антимикробната резистентност.“ Източник: actualno.com Още новини четете в: Здраве За още актуални новини: Последвайте ни в Google News
Нов Антибиотик - Новини
В продължение на повече от 50 години пред очите на
...... тестваме междинните продукти в пътищата на образуване на различните природни съединения, можем да открием нови, по-ефективни антибиотици за борба със супербактериите“, обобщава съавторът Грег Чалис.
Администрацията по храните и лекарствата на САЩ FDA разреши за
...... дали лекарството може да лекува гонорея, коментира Тони Ууд, главен научен директор на компанията.Очаква се Blujepa да бъде наличен през втората половина на тази година.
Американската администрация по храните и лекарствата във вторник одобри лекарството
...... лекарството, заедно с две други лекарства в развитието, Brexafemme и Tebipenem, да генерират пикови годишни продажби от повече от 2 милиарда паунда (2,59 милиарда долара).
Човешките черва в които има множество микроби разкриват потенциални нови
...... изглеждат готови за тестване срещу бактериални култури в лабораторията.Около половината от пептидите се оказват ефикасни в стопирането на бактериалния растеж.Изследването е публикувано в списание Cell.
Човешките черва в които има множество микроби разкриват потенциални нови
...... намален до 78 протеина, които изглеждат готови за тестване срещу бактериални култури в лабораторията. Около половината от пептидите се оказват ефикасни в стопирането на бактериалния растеж.
Човешките черва в които има множество микроби разкриват потенциални нови
...... в стопирането на бактериалния растеж.Изследването е публикувано в списание Cell.Всеки момент е важен! Последвайте ни в и , за да сте в крак с темите на деня
Човешките черва в които има множество микроби разкриват потенциални нови
...... за тестване срещу бактериални култури в лабораторията. Около половината от пептидите се оказват ефикасни в стопирането на бактериалния растеж. Изследването е публикувано в списание Cell.
Изследователи от Медицинския факултет на Вашингтонския университет в Сейнт Луис
...... на много лекарства и по-трудни за лечение. Нуждаем се от нови идеи и подходи, за да се борим ефективно с тях“, казва професор Скот Халтгрен.
Освен това новият вид антибиотично съединение което е дело на
...... бъде основа за редица тесноспектърни антибиотици, тъй като в клетъчни култури се бори активно срещу повече от 130 бактериални щама,... Прочетете целия материал в cash.bg
Една от най големите отрицателни страни на употребата на антибиотици е начинът по
...... на съпътстващите увреждания на чревния микробиом; този щадящ микробиома ефект би направил такива антибиотици по-добри за пациентите в сравнение с антибиотиците в настоящата клинична практика."
Комбинираният антибиотик Emblaveo aztreonam avibactam получи одобрение от Европейската агенция по
...... нива на чернодробните трансаминази и диария.В близките дни становището на регулатора ще бъде изпратено до EK за издаване на разрешение за търговия в целия ЕС.
Новият антибиотик е ефективен срещу мултирезистентни щамове бактерии в лабораторията
...... рибозомите, като произвеждат ензими, които нарушават способността на лекарството да се прикрепи към тях, този антибиотик много прилича на своята цел, за да бъде по-ефективен.
Новият синтетичен антибиотик е ефективен срещу мултирезистентни щамове бактерии в
...... до голяма степен изоставена от големите фармацевтични компании поради икономически съображения; това предоставя възможност за академични лаборатории като нашата наистина да окажат въздействие“, каза той.
Комитетът за лекарствени продукти в хуманната медицина CHMP при Европейската
...... продължителността на неутропенията и честотата на фебрилна неутропения, дължаща се на химиотерапия.Одобрен е и един генеричен продукт - Niapelf (палиперидон), предназначен за лечение на шизофрения.
Учените са открили изцяло нов клас антибиотици които убиват една
...... като, за да влязат в клинични изпитвания, те трябва да бъдат произведени по определени стандарти, но инвестициите в производствените предприятия зависят от успешните клинични изпитвания.
Учените са открили изцяло нов клас антибиотици които убиват една
...... като, за да влязат в клинични изпитвания, те трябва да бъдат произведени по определени стандарти, но инвестициите в производствените предприятия зависят от успешните клинични изпитвания.
Учените са открили изцяло нов клас антибиотици които убиват една
...... влязат в клинични изпитвания, те трябва да бъдат произведени по определени стандарти, но инвестициите в производствените предприятия зависят от успешните клинични изпитвания. Последвайте канала на
Учените са открили изцяло нов клас антибиотици които убиват една
...... като, за да влязат в клинични изпитвания, те трябва да бъдат произведени по определени стандарти, но инвестициите в производствените предприятия зависят от успешните клинични изпитвания.
Учените са формулирали нов тип антибиотик който има потенциала да
...... към антимикробни инфекции инфекции, но поставя основата за бъдещи лекарства, използващи същия механизъм. Учените наскоро публикуваха резултати от техните експерименти, включващи Zosurabalpin в списанието Nature.
Учени от Швейцария обявиха откриването на нов клас антибиотици за
...... разработване на нови антибиотици и да го направи „по-ефективен и рационализиран“..Мелиса Руди е здравен редактор и член на екипа за лайфстайл във Fox News Digital.
Открит е антибиотик от нов клас който показва много добър
...... се появи нов клас антибиотици срещу тежки CRAB инфекции“, коментират двама от авторите на публикациите в Nature - д-р Морган Гугер и д-р Паул Хегенротер.
Открит е антибиотик от нов клас който показва много добър
...... се появи нов клас антибиотици срещу тежки CRAB инфекции“, коментират двама от авторите на публикациите в Nature - д-р Морган Гугер и д-р Паул Хегенротер.
Учените казват че са разработили нов тип антибиотик за лечение
...... го стигнем до мястото, където е сега, и има още много клинични изпитвания, преди да може да се определи дали това е лекарство или не.“
Зосурабалпин победи щамове на пневмония и сепсис при мишки повишавайки
...... зависеха от успешни клинични изпитвания. Лаборатория Розалинд Франклин в Уест Мидландс, която първоначално беше създадена за обработка на тестове за Covid по време на пандемията.
Учени са използвали изкуствен интелект AI за да открият нов
...... коментира, че идеята за използване на AI е "голяма промяна на играта, развълнувана съм да видя работата, която той (д-р Стоукс) върши, тя ще спаси животи".
Учени са използвали изкуствен интелект AI за да открият нов
...... която той (д-р Стоукс) върши, тя ще спаси животи". СЗО отчете повишена резистентност на бактерии срещу антибиотици Причина за това е прекомерната употреба на антибиотици
Учени от САЩ разработиха нов антибиотик с помощта на изкуствен
...... които са силно резистентни към лекарства. Изкуственият интелект е бил използван за синтезиране на химичните съединения. По този начин значително е било съкратено времето за тестване.
Учени от Съединените щати разработиха нов антибиотик с помощта на
...... които са силно резистентни към лекарства.Изкуственият интелект е бил използван за синтезиране на химичните съединения. По този начин значително е било съкратено времето за тестване.
Учени използваха изкуствен интелект за да открият нов антибиотик който
...... рани, както и да убива бактерията в проби от пациенти.Според медиците разработката на антибиотиците, открити от ИИ, може да стигнат до аптеките през 2030 г.
Учени от Канада и САЩ са използвали изкуствен интелект за
...... лекарства, чиято точна химическа структура е известна, и ги тестват върху Acinetobacter baumannii, за да установят кое може да забави бактерията или да я убие.
След откриването на пеницилина от Александър Флеминг през 1928 г
...... Zaidín на Испанския съвет за научни изследвания в Гранада. „Трябва да се отворим за изследване на всичко, което е фауна, за да намерим нови антибиотици."Източник
Учени от Калифорнийския университет в Санта Барбара създадоха широкоспектърен антибиотик
...... В бъдеще се планират допълнителни проучвания за определяне на безопасността и ефикасността на лекарството при хора, за да се определят всички клинични ползи и рискове.
Немски учени откриха антибиотик който е достатъчно мощен да убие
...... инфектира кръвта и сърцето.Тестовете са установили, че Lugdunin убива и друг опасен вид бактерия, наречена VRE – Ванкомицин-резистентни ентерококи.Предстои лекарите да тестват новия антибиотик върху хора.
Учени от университета в Тюбинген Германия обявиха че са открили
...... от човешкото тяло. Има около 1000 вида бактерии, които нормално населяват тялото на човека. Всяка от тях може да е ключ към бъдещ медицински пробив.
Два вида фунгус са изолирани от силно токсична мина в
...... че действа по съвсем различен начин от досега познатите антибиотици. Справил се е успешно със Bacillus anthracis, Streptococcus pyogenes, Candida albicans и Candida glabrata. Източник: Science Alert
Фирмите Бионтех и Пфайзер ще започнат изпитвания върху хора на
...... общественото здравеопазване общият брой на хората, които умират годишно от резистентни на антибиотици инфекции в САЩ и Европейският съюз, се приближава до 70 хиляди души.
Екип от британски учени работи върху нов антибиотик който може
...... масова употреба. По данни от проучване на списание "Лансет", само през 2019 година повече от 1,2 милиона души са починали от резистентни на антибиотици бактериални инфекции.
Екип от британски учени работи върху нов антибиотик който може
...... употреба. По данни от проучване на списание „Лансет“, само през 2019 година повече от 1,2 милиона души са починали от резистентни на антибиотици бактериални инфекции.
1000 годишно лекарство открито от учени в средновековен ръкопис може да
...... своята ефективност операции и химиотерапии, например, биха станали прекалено опасни за пациентите.Според д-р Харисън откритият средновековен лек би могъл да се използва в клиничната практика.
Атакува разнообразна група бактериални клеткиНов антибиотик откриха учените в корените
...... рибозома, като потиска способността ѝ да произвежда протеини. Откривателите на ценния препарат очакват той да бъде използван за ускоряване растежа на много бобови растения.
Екзотичен антибиотик е открит в кореновите възли на дивия растящ
...... новия антибиотик предполагат, че той може да се прилага при ускоряване растежа на много бобови растения. Материалът за откритието е публикуван в списание Nature Communications.
Американската администрация по храните и лекарствата FDA одобри на 19
...... като квалифициран продукт от инфекциозни заболявания (QIDP). Обозначението QIDP се дава на антибактериални и противогъбични лекарствени продукти, предназначени за лечение на сериозни или животозастрашаващи инфекции.
Специалисти от университета Браун получиха нов вид антибиотик който е
...... отслабен имунитет, тя се предава лесно. Новото лекарство атакува механизма на оцеляване на бактерията, като разрушава външния й слой. Така тя трудно би станала резистентна.
Специалисти от университета Браун получиха нов вид антибиотик който е
...... имунитет, тя се предава лесно. Новото лекарство атакува механизма на оцеляване на бактерията, като разрушава външния й слой. Така тя трудно би станала резистентна.
Една от най честите причини за стомашния дискомфорт е проявата на
...... ПроВиотик Хеликобактер е напълно натурален, растителен продукт, не съдържа никакви консерванти, алергени и е напълно безвреден. Поръчайте го сега на www.smartbio.bg PR публикация
ИАЛ ще вземе участие в процедуратаИзпълнителната агенция по лекарствата ИАЛ
...... агенция.Процедурата и нейните оценители са гласувани на заседанието на Committee for Medicinal Products for Human Use (CHMP) към Европейската агенция по лекарствата (ЕМА) през септември.
Протеин произвеждан от медоносните пчели може да помогне на учените
...... вредните бактерии. Той се съдържа в пчелите, осите и стършелите, като ги предпазва от инфекции. Специалистите се опитват да го синтезират в лабораторна среда.